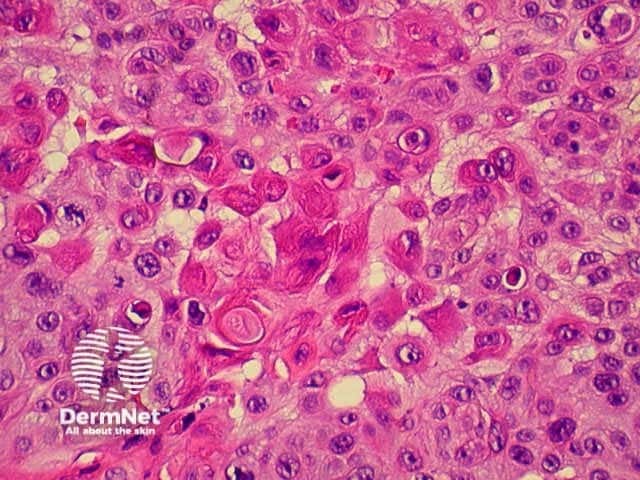
Squamous cell carcinoma

Main menu
Common skin conditions
NEWS
Join DermNet PRO
Read more
Quick links
Created 2008.
This section discusses squamous cell carcinoma and its common precursor lesions, actinic keratoses.
About 50,000 new cases of non-melanoma skin cancer are estimated to occur in New Zealand each year – by far the most common of all cancers. There were 63 deaths in 1996. The majority of these had squamous cell carcinoma.
The solar (actinic) keratosis is the most common precursor lesion for squamous cell carcinoma. Histologically, atypical keratinocytes are found in the basal layer of the epidermis.
Actinic keratoses are found on sun-exposed sites, mainly face, ears and hands. They are often multiple and have a hard scaly surface without induration (which would indicate dermal infiltration i.e. squamous cell carcinoma). The degree of scale and redness is variable, and the lesions frequently remit spontaneously.
Actinic keratoses on the lips are often referred to as ‘actinic cheilitis’; this term is also sometimes used to refer to an uncommon photosensitive dermatitis that affects the lips.
Inflamed actinic keratosis Non-scaly actinic keratosis Diffuse actinic keratoses Hypertrophic actinic keratosis Solitary actinic keratosis Diffuse keratoses Pigmented actinic keratosis Actinic cheilitis 







Actinic keratoses are predominantly treated by cryotherapy. They may also be treated with the following:
Cryotherapy blisters Fluorouracil dermatitis Reaction to imiquimod Keratoses marked out for PDT 



Cutaneous horn is the name given to a solitary horny lesion; histologically these may be reported as hyperkeratotic actinic keratosis or well differentiated squamous cell carcinoma. They are treated by local shave, curette and cautery or excision.
Cutaneous horn Cutaneous horn Cutaneous horn Cutaneous horn 



Squamous cell carcinoma in situ usually presents as one or more slowly enlarging erythematous scaly plaques, known as Bowen's disease. Histologically, atypical keratinocytes are found throughout the epidermis without invasion through the basement membrane.
Bowen disease Bowen disease Bowen disease Bowen disease 



Squamous cell carcinoma in situ may be treated surgically. Other treatments include cryotherapy, 5-fluorouracil cream, imiquimod cream or photodynamic therapy (PDT).
Cryotherapy Fluorouracil ulceration Crusting from PDT Infected excessive 



Intraepithelial carcinoma affecting anogenital regions (penis, scrotum, vulva) is not discussed here.
Keratoacanthoma is a rapidly growing dome-shaped nodule with a keratinous core. These lesions may resolve spontaneously. However, they should usually be removed surgically by formal excision or shave, curettage and cautery as it is not possible to determine which lesions will resolve. Histologically, clinically diagnosed keratoacanthomas often prove to be well differentiated squamous cell carcinoma. A true keratocanthoma is characterised by a keratin-filled crater with well-differentiated keratinocytes extending over both sides of the crater like ‘lips’, and without dermal invasion.

Keratoacanthoma

Keratoacanthoma

Keratoacanthoma

Keratoacanthoma
Cutaneous invasive squamous cell carcinoma (SCC) generally arises within a actinic keratosis or within SCC in situ. Rarely, it arises within a thermal burn or chronic skin disease such as discoid lupus erythematosus. Lip cancer predominantly affects the lower lip. It particularly occurs in males chronically exposed to the sun and is more frequent in smokers.
SCC presents as an irregular keratinous nodule or a firm erythematous plaque, and frequently ulcerates. Histologically, atypical keratinocytes proliferate within the dermis.
Metastatic disease is uncommon. There were 86 deaths from non-melanoma skin cancer registered in New Zealand in 2000; most of these were SCC.

Squamous cell carcinoma

Squamous cell carcinoma of the lip

Squamous cell carcinoma

Squamous cell carcinoma

Squamous cell carcinoma

Squamous cell carcinoma

Squamous cell carcinoma

Squamous cell carcinoma
Invasive SCC is nearly always treated surgically. Wide margins are advisable for poorly differentiated or anaplastic tumours. Some tumours are treated by radiotherapy, particularly when surgery is difficult or incomplete.
Malignant follicular tumours are considered equivalent to low-grade squamous cell carcinomas. Sebaceous carcinoma is most often seen around the eyelid but may occur elsewhere on head, neck or trunk. They are variably differentiated and have significant metastatic potential. Adnexal carcinomas with tubular and ductular differentiation (adnexal adenocarcinomas) are relatively uncommon. They often arise within a benign adnexal lesion. There are various subtypes, and they generally have low risk of metastasis.
The histological characteristics of keratinocytic tumours are illustrated below.

Actinic keratosis

Actinic keratosis

Squamous cell carcinoma
Squamous cell carcinoma
What are published recurrence rates for actinic keratoses treated by different modalities? Discuss the evidence for the effectiveness of sunscreens in the management of actinic keratoses.
Information for patients
See the DermNet bookstore.